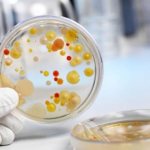
image

Анализ на трихомониаз назначается пациентам, имеющим признаки инфекционного заболевания мочеполовой системы. Согласно статистическим данным, у более 50% мужчин и женщин, обратившихся по поводу уретрита, эндометрита и других патологий, в ходе лабораторного исследования были выявлены Trichmonas vaginalis. Эти патогенные бактерии паразитируют в человеческом организме и вызывают воспалительные процессы в органах и системах. Трихомониаз передается преимущественно половым путем, но существует вероятность развития заболевания при бытовых контактах.
Особенности трихомониаза
Прежде чем разбираться, что значит, если мазок показал трихомониаз, необходимо понять, что это вообще за инфекция. И чем она может быть опасна для человека.
Трихомониаз – заболевание, что вызывается патогенными микроорганизмами, называемыми влагалищными трихомонадами.
Важно понимать, что микроорганизм не является бактерией в полном смысле слова, относясь к группе простейших. Это одноклеточный микроорганизм, способный поглощать бактерии, эритроциты, эпителиальные клетки в различных органах и тканях.
Именно способность поглощать клетки эпителия и эритроциты превращает трихомонаду в патогенный микроорганизм.
Как отмечают доктора, трихомониаз – это инфекция, распространяющаяся в основном половым путем. Заразиться болезнью можно при незащищенном сексуальном контакте.
Однако в некоторых случаях заражение является следствием игнорирования правил личной гигиены. Также патогенный микроорганизм способен передаваться от больной женщины ребенку во время родового процесса.
Важно помнить о том, что выделяется довольно большое количество различных трихомонад (более 50 видов всего). При этом лишь некоторые виды живут в организме человека, а симптомы трихомониаза провоцирует только влагалищная разновидность.
Следовательно, обнаружение других видом трихомонады не говорит о том, что человек болен конкретной болезнью.
Как проявляется урогенитальный трихомониаз у женщин?
После контакта с инфицированным человеком трихомонады попадают на слизистые мочеполового тракта здорового.
Они закрепляются на эпителиальных клетках, распространяются в лакуны и железы и могут спровоцировать процесс воспаления.
Практически у 85% больных заболевание сочетается с иными инфекциями (микоплазмозом, уреаплазмозом, гонореей, кандидозом, бактериальным вагинозом, хламидиозом).
Кроме того, трихомониаз облегчает инфицирование ВИЧ и иными половыми инфекциями (хламидиями, гонококками, онкогенными папилломавирусами).
При этом у 80% лиц мужского пола болезнь не имеет симптомов (в редких случаях диагностируется трихомонадный уретрит).
Тогда как у лиц женского пола она обычно проявляется в форме специфического вагинита (иначе кольпита).
С какими жалобами сдают мазок на трихомониаз
Часто люди хотят знать о том, в каких случаях сдается мазок на трихомониаз женщинами или мужчинами. В большинстве случаев доктора не направляют пациента на исследование просто так.
Чтобы человек оказался в лаборатории для забора материала, у него должны наблюдаться определенные симптомы, свидетельствующие о заражении.
Среди них:
- появление выделений нетипичного вида из мочеиспускательного канала у представителей сильного пола или у женщин из влагалища
- появление покраснения на кожных покровах половых органов
- обнаружение гиперемии слизистых оболочек во время гинекологического или урологического осмотра
- обнаружение признаков отечности как кожных покровов в области гениталий, так и слизистых оболочек
- жалобы на появление болезненности при попытках заняться сексом, что больше характерно для женин, но в запущенных случаях встречается и у представителей сильного пола
- появление различных неприятных ощущений при мочеиспускании, нарушения в этом процессе вплоть до формирования ложных позывов
Однако всегда существует вероятность того, что помимо трихомонады в организме больного будут обнаружены другие патогенные микроорганизмы. Так, например, трихомониаз нередко сочетается с гонококковой инфекцией. Из-за этого нередко рекомендуется сдавать мазок на гонорею и трихомониаз одновременно, чтобы в последующем не проходить сдачу материала повторно.
Особенно актуальна эта рекомендация для представителей сильного пола. Для них получение образцов из области уретры – процесс неприятный.
Какие заболевания вызывает вагинальная трихомонада?
Инфицирование может стать причиной следующих, различаемых Международной классификацией болезней, вариантов трихомониаза:
- собственно урогенитальный (например, лейкоррея вагинальная)
- иных локализаций
- неуточненный
- трихомонадный простатит
Согласно клинической классификации, урогенитальный трихомониаз подразделяется на:
- свежий (подострый, торпидный – стертый, острый) – давность заболевания не превышает два месяца
- хронический – отличается торпидным течением и давностью свыше двух месяцев (или неустановленной продолжительностью)
- трихомонадоносительство – трихомонады обнаруживаются лабораторно, но симптомов болезни нет (такое состояние часто выявляется у мужчин, которые при отсутствии признаков болезни остаются источником заражения)
Дополнительные поводы для сдачи мазка на трихомониаз
Однако, как отмечают врачи, для взятия мазков на гонорею и трихомониаз не обязательно наличие яркой симптоматики. В некоторых случаях исследование назначается даже в том случае, если у пациента нет никаких ярких жалоб на свое состояние.
Например, это необходимо при:
- планировании беременности (для женского организма, а также организма, развивающегося в нем младенца присутствие влагалищных трихомонад может быть негативным фактором, приводящим к различным осложнениям)
- поиске причин бесплодия (трихомониаз обладает способностью к бессимптомному течению, из-за чего нередко больные даже не знают о своей патологии, но из-за воспалительных процессов в половых органах ребенка зачать не могут)
- подготовке к ЭКО (искусственное оплодотворение – недешевая и непростая процедура, а потому необходимо исключить все патологии, что могут стать помехой для ее успешного осуществления)
- ранних сроках беременности (эта мера необходима, так как даже в период беременности женщинам рекомендуется проходить терапию от трихомониаза, если анализ оказывается положительным)
- активной половой жизни с разными партнерами (частая смена половых партнеров способствует развитию инфекционных заболевания, передаваемых половым путем, включая трихомониаз)
- обнаружении каких-либо половых инфекций у сексуального партнера (важно провести проверку своего организма, так как даже при контактах с презервативом сохраняется вероятность заражения, хоть и более низкая, чем без них)
- случайном контакте с партнером, в котором нет уверенности без защиты с помощью контрацептива (в этом случае риск инфицирования довольно высок, о чем важно помнить, а потому стоит тщательно провериться)
Читать также Симптомы проявления трихомониаза у мужчин
При всех этих показаниях симптомы трихомониаза могут полностью отсутствовать. Более того, само заражение может отсутствовать. Тогда исследование носит чисто профилактическую цель.
Предназначается для того, чтобы убедиться в отсутствии патологического паразита в организме.
Расшифровка: нормы и отклонения
В некоторых случаях возможно получение сомнительного результата лабораторного исследования. При получении пограничных данных врачи рекомендуют сдать анализ повторно через 10 дней.
Мазок на трихомониаз: особенности подготовки
Как и при любом другом обследовании, при поиске трихомонад важна подготовка к мазку на трихомониаз. Если пренебречь рекомендациями по подготовке, результаты могут оказаться недостоверными.
В лучшем случае доктор направит пациента на повторную сдачу анализов. В худшем случае лечение будет подобрано неверно или вовсе не подобрано.
Патологический микроорганизм продолжит наносить телу пациента вред.
Рекомендации для представительниц слабого пола и мужчин довольно однотипны.
Женщинам рекомендуется отказаться от использования вагинальных свечей, тампонов, таблеток с антисептиками или антибиотиками, чтобы исключить воздействие препаратов.
Мужчинам придется избегать инстилляций в уретру.
Важно прекратить использование медикаментов минимум за неделю, чтобы они успели вывестись из организма.
Дополнительно всем, кто планирует проходить исследование, рекомендуется:
- отказаться от сексуальных соитий минимум на 48 часов до посещения кабинета доктора
- постараться не проводить гигиенических процедур с использованием антибактериальных средств, ограничившись простой водой из-под крана
- выполнять исследование только через 5 дней после того, как последний раз использовались спермициды
Простые правила подготовки, как отмечают доктора, позволят получить достоверные результаты. Это в интересах самого пациента, так как повторное исследование может быть дискомфортным, если речь идет о мужчине. Дополнительно удастся сэкономить в том случае, если анализ сдается платно.
Как берут
Взятие венозной крови, мочи, семенной жидкости осуществляется утром. Контейнер для анализов необходимо подготовить заранее. Он должен быть стерильным и герметичным. Урина, сперма собирается дома. Мазок на микрофлору осуществляется при осмотре у гинеколога.
Кровь из вены сдается натощак, с 8 до 11 часов. Процедуру проводят с применением одноразового шприца или вакуумной системы, состоящей из пробирки с химическими реактивами, иглы и устройства-держателя. Пациент располагается на стуле рядом с медицинским столом. Его рука фиксируется с поднятой вверх ладонью с помещением локтя на специальный валик. После наложения жгута и обработки поверхности кожи ватным тампоном со спиртом медицинский работник вводит иглу в вену. По окончании забора крови пациент должен согнуть руку на несколько минут вместе со стерильным бинтом, смоченным в антисептике.
Особенности забора мазка на трихомониаз с гонореей
Мазок на трихомониаз у мужчин может стать источником серьезного дискомфорта. Дело в том, что для забора материала доктору придется проникнуть специальными инструментами в уретру.
Если этого не сделать, собрав, например, мочу для исследования, результат может оказаться ненадежным. Именно поэтому рекомендуется инвазивная методика. Даже несмотря на то, что для представителей сильного пола она неприятна.
У женщин, в отличие от мужчин, проблем с забором образцов для обследования на трихомониаз с гонореей нет. У них материал берут из трех точек, но сама процедура совершенно безболезненная.
Единственный дискомфорт, что может испытать женщина – это дискомфорт от контакта с инструментарием. Он может отличаться по температуре от ее слизистых оболочек.
Если планируется сдавать комплексный анализ на сочетание трихомонады и заражения гонококком, особенности забора необходимых образцов ничем не отличаются.
Стоимость анализа и где сдать
Анализы на трихомониаз можно сдать в следующих лабораториях:
- Инвитро. Исследования проводятся методом ИФА и занимают 5 рабочих дней. Стоимость — 12,54 $. Цена процедуры взятия биоматериала составляет 3,5$.
- Синево. Анализы крови с выявлением иммуноглобулинов IgG выполняются в течение 3 рабочих дней и стоят 8,4$.
- Центр молекулярной диагностики CMD. Услуги по исследованию биологического материала с определением РНК методом NASBA стоят 25,1$. Срок выдачи результатов — через 1-2 дня. Стоимость анализа с качественным определением ДНК составляет 5,6$. Цена на количественный метод — 7,4$. Результаты предоставляются в течение 1-3 дней.
Исследования биоматериала на трихомониаз проводятся с использованием сразу нескольких лабораторных методов. Комплексные диагностики, включающие серологические, иммуноферментные, микроскопические и культуральные анализы, позволяют врачам поставить точный диагноз и правильно подобрать медикаментозные препараты. Если результат ложноположительный или сомнительный, назначаются повторные исследования. Достоверность данных зависит не только от квалификации работников лаборатории и качества реактивов, но и от соблюдения пациентами правил подготовки к сдаче биологического материала.
Забор мазка на трихомониаз с флорой
Заболевания, передающиеся половым путем, отличаются тем, что большинство из них нельзя достоверно определить с помощью самого простого исследования – микроскопического. Однако трихомониаз – редкое исключение из правил в наборе ЗППП.
Инфекция определяется под микроскопом, а само исследование в этом случае называется мазком на флору. Мазок трихомониаз на флору получается также, как и стандартный мазок.
Другое дело, что его рекомендуется оценить под микроскопом в течение ближайшего часа.
Трихомонады относятся к классу простейших. Они способны двигаться и имеют специфическую форму.
Благодаря чему появляется возможность не спутать их с другими микроорганизмами.
Подобное обследование называют исследованием нативного мазка. Стоит иметь в виду, что оно будет бесполезно в том случае, если проводится через промежуток времени более часа после того, как образцы были взяты у пациента.
Важно иметь в виду, что нативный мазок на флору не всегда эффективен.
В диагностический материал могу просто не попасть трихомонады. Из-за чего исследование окажется отрицательным, хотя патогенные микроорганизмы в теле пациента присутствуют. В связи с этим даже отрицательные результаты подобного метода перепроверяют с помощью других исследований.
Анализ на трихомонады: как проводят расшифровку
Анализ на трихомонады у женщин и представителей сильного пола расшифровывается по одному и тому же принципу.
В первую очередь определяют, положительный он или отрицательный. Если в соответствующей графе виднеется надпись «положительно», значит избежать заражения не удалось. В этом случае пациенту рекомендуется начать лечение. Чтобы уберечь себя от осложнений заболевания и избавиться от неприятных симптомов, если они есть. Если в графе виднеется надпись «отрицательно», значит все не так уж и плохо.
По крайней мере, больной не страдает от трихомониаза, и может не получать терапии по поводу этого заболевания. Важно иметь в виду, что результаты могут быть ошибочными. Оценивать их без помощи доктора не рекомендуется именно из-за этой вероятности. Ведь пациент может неверно расценить связь результатов и клинической симптоматики и, например, просмотреть недуг, не начав его лечение. Также некоторые пациенты, склонные к мнительности, могут увидеть заболевание там, где его нет, и тоже начать терапию, которая принесет в этом случае больше вреда, чем пользы.
Мазок на трихомониаз: обнаружение разрушенных клеток
Часто пациенты задаются вопросом о том, что значат разрушенные клетки в мазке на трихомониаз. На самом деле ничего сложного в этом показателе нет.
Трихомонада – типичный паразит, разрушающий нормальные клетки организма пациента. Естественно, оказавшись у пригодных для своего размножения условиях, она начинает уничтожать окружающие ткани.
Однако бесследное уничтожение – нечто невозможное. Из-за этого в мазке можно обнаружить фрагменты разрушенных клеток.
Врачи отмечают, что помимо фрагментов разрушенных клеток в результатах можно будет найти большое количество лейкоцитов. Это стандартная реакция организма на вторжение патогенных бактерий или простейших.
Лейкоциты обеспечивают иммунный ответ и являются типичными маркерами воспалительного процесса.
Помимо лейкоцитов в патологическом очаге также можно будет найти клетки эпителия в большом количестве. Они появляются из-за отшелушивания нормальных клеток от слизистых оболочек.
Клинические проявления
Период инкубации при трихомониазе составляет от 1 до 4 недель. Чаще всего первые симптомы появляются спустя 1,5-2 недели с момента заражения. У некоторых больных симптомы совсем отсутствуют. Если трихомониазом заразилась женщина, могут наблюдаться следующие симптомы:
- покраснение наружных половых органов;
- зуд;
- жжение;
- дизурические явления (боль при выведении мочи, поллакиурия);
- отечность тканей в области преддверия влагалища;
- неприятные ощущения во время половых контактов;
- выделения из половых органов;
- ноющие боли в нижней части живота.
Наиболее частый симптом заболевания — нехарактерные выделения. Они могут быть желтого или зеленого цвета. Выделения имеют неприятный запах. Подобные симптомы заставляют женщин обратиться к врачу. При осложненном течении трихомониаза у женщин возможно развитие эндометрита, сальпингита или оофорита. Предрасполагающим фактором поражения внутренних половых органов является период менструации, проведение абортов. Заболевание протекает наиболее тяжело у ослабленных лиц.
Мужчины часто переносят трихомониаз бессимптомно. Возможными проявлениями заболевания могут быть:
- боль во время выведения мочи;
- признаки воспаления предстательной железы;
- выделение крови из уретры;
- слизистые или гнойные выделения из наружного мочеиспускательного отверстия.
Трихомонады негативно влияют на качество семенной жидкости. Эти микроорганизмы могут обнаруживаться в сперме в большом количестве. При отсутствии лечебных мер нарушается сперматогенез и развивается бесплодие.
Особенности ПЦР мазка на трихомониаз
ПЦР мазок трихомониаза – еще одна популярная форма исследования полученных от пациента образцов.
Популярность объясняется в первую очередь тем, что диагностика показывает высокую достоверность.
Помогает избежать тех ошибок, что обычно совершаются при микроскопическом исследовании.
ПЦР – современная методика, относящаяся к молекулярно-генетическим методам. Исследование часто используют, чтобы подтвердить другие результаты анализов. Объясняется это тем, что анализ довольно дорогой, из-за чего использовать его в качестве скринингового нет возможности.
ПЦР направлена на то, чтобы обнаружить ДНК возбудителя в биологическом материале, полученном от больного. Особенностью исследования является то, что оно нацелено не на поиск следов патологического организма, а на поиск самого организма. Это делает его более надежным, достоверным.
Читать также Передается ли трихомониаз бытовым путем
Как отмечают доктора, с помощью ПЦР может также исследоваться кровь пациента. В ней трихомонады также могут циркулировать, благодаря чему анализ окажется положительным.
ДНК уникально для каждого живого организма на планете. Вероятность ошибок при ПЦР сводится к минимальным значениям. В основном обусловлена ошибками при взятии материала или неверным использованием реагентов.
Особенности посева мазка на трихомониаз
Посев мазка на трихомониаз – еще одно исследование, что нередко рекомендуется докторами людям с подозрением на эту инфекцию. Посев считается одним из самых достоверных вариантов диагностики.
Но вместе с тем он является довольно дорогим и долгим методом исследования. Для сравнения, если результаты ПЦР можно получить в тот же день, то для оценки результатов посева требуется минимум неделя. Так как микроорганизмы должны вырасти на питательной среде.
Посев – исследование, при котором реже всего совершаются ошибки.
Ложные результаты возможны лишь в том случае, если не соблюдались рекомендации по засеванию питательной среды образцами.
Зато параллельно с подтверждением диагноза при посеве доктор может произвести выбор терапии. Для этого на питательную среду помещают кружочки, пропитанные антибиотиками.
В зависимости от того, где рост микроорганизмов будет отсутствовать, делают вывод о том, к какому препарату чувствителен патоген, обнаруженный у больного человека. Естественно, при лечении отдается предпочтение тому препарату, к которому микроорганизм проявил наибольшую чувствительность.
Что такое трихомонады в мазке с половых органов
Многие женщины задаются вопросом: трихомонады в мазке, что это такое? Это одно из уретрогенитальных инфекционных заболеваний. Если вовремя не приступить к лечению такого воспалительного процесса, может возникнуть множество негативных последствий и еще более серьезных патологий в человеческом организме.
Что такое трихомониаз
Часто при профилактических осмотрах у женщин и мужчин врач диагностирует наличие трихомониаза. Трихомониаз — одно из заболеваний, которое передается половым путем. Может возникать как у мужчин, так и у женщин. Следует учитывать, что передача инфекции возможна в случае следующих половых контактов:
- орально-вагинального;
- анального;
- анально-вагинального.
Возбудителем воспалительного процесса являются одноклеточные микроорганизмы — трихомонады. Как правило, они не могут существовать во внешней среде, поэтому чаще всего поражают влагалище, реже — женские придатки или матку, уретру или выводные протоки. Согласно медицинской статистике, около 70 % женщин, у которых имеются влагалищные выделения, подвергаются заражению трихомонадами.
Основные симптомы, которые сопровождают данную болезнь, следующие:
- появляется покраснение в области промежности или гениталий;
- наблюдается отечность половых органов;
- слизистая оболочка влагалища раздражается, что провоцирует появление кровотечений;
- увеличивается количество различных выделений из влагалища;
- могут наблюдаться кровяные сгустки в выделениях;
- мочеиспускание становится более частым и сопровождается острыми, резкими болями;
- появляются зуд, жжение в органах мочеполовой системы или с внутренней стороны бедер;
- болезнь может сопровождаться болезненными ощущениями в нижней части брюшной полости или поясницы.
Заболевание может проявляться в острой форме, при тяжелом течении оно становится хроническим. У женщин при переходе воспалительного процесса из одной формы в другую возникают дискомфортные ощущения, как правило, только до или после менструации.
Очень часто трихомониаз проявляется совместно с другими инфекционными заболеваниями. Именно поэтому симптоматика может быть различна. При обнаружении одного или нескольких вышеуказанных симптомов следует незамедлительно обратиться к врачу для проведения диагностики. Для того чтобы диагностировать наличие данной инфекции в организме, необходимо исследовать мазок из влагалища. Определение возбудителя заболевания таким способом является наиболее точным и недорогим.
Основные причины болезни
Это инфекционное заболевание в большинстве случаев от человека к человеку передается половым путем.
Существует ряд причин, которые влияют на возникновение воспалительного процесса, основными среди них являются следующие:
- 1Изменение уровня кислотности содержимого влагалища. Как правило, проявляется в период перед началом менструации и после ее завершения.
- 2Медицинские аборты и возможные последствия, которые их сопровождают.
- 3Роды, что связано с нарушением защитного механизма, так как происходит расширение мышц шейки матки.
- 4Половой контакт, который провоцирует всасывание инфекции во внутренние половые органы (во время оргазма).
Трихомониаз в зависимости от существующих симптомов и длительности течения заболевания может развиваться в следующих формах:
- острая или подострая форма, которую еще часто называют «свежим» трихомониазом, может протекать в некоторых случаях даже бессимптомно;
- хроническая, которая развивается по истечении двух месяцев, если не проводить лечение воспаления;
- трихомонадоносительство.
Инкубационный период воспалительного процесса примерно составляет от четырех дней до двух недель. Таким образом, симптоматика проявляется уже на пятый день после заражения.
Возможные последствия заболевания
Заболевание в хронической форме может привести к следующим негативным последствиям:
- 1Непроходимости труб матки или воспалению маточных придатков. Результатом таких патологий в большинстве случаев является женское бесплодие.
- 2Расстройствам половых органов, которые проявляются в виде фригидности или аноргазмии у женщин.
- 3Осложнениям во время беременности. Инфекция может провоцировать преждевременные роды или инфицирование будущего ребенка. Кроме того, в результате данного заболевания может развиваться уродство плода, гипоксия (нехватка кислорода в утробе).
- 4Поражению женских яичников и их воспалению. При этом нарушается эндокринная функция, что негативно воздействует на беременность в целом.
- 5Гибели плода в результате влияния токсинов, выделяемых возбудителями инфекции.
- 6Инфицированию плаценты, если трихомонада развивается в организме совместно с другими инфекциями.
- 7Развитию воспалительных процессов яичников и маточных труб, что сопровождается болезненными ощущениями внизу живота во время полового акта.
- 8Развитию доброкачественных или злокачественных новообразований женских половых органов.
Кроме того, в результате проведенных современных медицинских исследований выявлено, что трихомонада может являться причиной возникновения сахарного диабета, различных аллергических реакций и мастопатии.
Развитие данной инфекции может привести к непоправимым негативным последствиям для организма. Если есть подозрение на заболевание, следует обратиться к врачу, который поставит диагноз и назначит необходимый курс терапии. Ни в коем случае нельзя заниматься самодиагностикой и самолечением. Правильный диагноз может поставить только лечащий врач после проведения всех необходимых для диагностики процедур.
Методы лечения и профилактики
Профилактика трихомонизоальной инфекции может включать в себя следующие меры:
- 1Половые контакты только с одним постоянным партнером, которому женщина доверяет и может быть уверена в нем.
- 2Защита полового акта с помощью барьерных контрацептивов. В данном случае идеальным вариантом является использование презерватива.
- 3Соблюдение личной и интимной гигиены. Необходимо всегда пользоваться только своим полотенцем, мочалкой и другими банными принадлежностями.
- 4Прохождение постоянного медицинского и гинекологического осмотра. В обязательном порядке такой осмотр должен осуществляться не реже, чем два раза в год. Если возникают какие-либо беспокоящие симптомы, следует незамедлительно обратиться к врачу.
Существуют специальные медицинские препараты, которые можно применять в случае, если произошел незащищенный половой акт. Такие лекарственные средства уменьшают риск заражения инфекцией примерно на 70 %. Обязательным условием является оперативная обработка влагалища специализированными медикаментами в течение часа или двух после полового акта.
Терапевтическое лечение, которое назначает лечащий врач, заключается в приеме лекарственных препаратов. При этом следует учитывать, что пройти данный курс лечения нужно обоим партнерам независимо от того, у кого выявлена инфекция в организме.
Важным условием лечения является полный отказ от употребления алкогольных напитков и острых блюд, специй. Чтобы снизить риск рецидива, следует отказаться на время лечения от половых контактов.
Группа медицинских препаратов, которые используются при лечении данного заболевания, направлена на полное подавление жизнедеятельности анаэробных микроорганизмов. Терапия хронической и острой форм воспаления одинакова. Дополнительно при хронической форме назначается прием лекарств, которые повышают иммунитет, снабжают организм нужными витаминами и микроэлементами. Основные лекарственные препараты, которые уничтожают возбудитель инфекции в организме, — это группа 5-нитроимидазолов. К ним относят такое медицинское средство, как метронизадол, и все его аналоги. Лекарство назначается врачом с учетом особенностей организма пациента.
mydoctorhouse.ru>
Мазок на трихомониаз: когда рекомендуется сдача материала и оценка после терапии
Часто среди пациентов звучит вопрос о том, когда после заражения мазок на трихомониаз можно сдавать.
Важно понимать, что идти к доктору за направлением на анализ сразу не имеет смысла. Ведь исследование в этом случае ничего не покажет.
Даже если будут использованы очень современные методы с высокой чувствительностью. Объясняется это особенностями инкубационного периода микроорганизма.
Дело в том, что простейшему необходимо некоторое время, чтобы размножиться в теле пациента в достаточном количестве и начать наносить ему вред. Пока не будет превышен порог чувствительности анализов, все исследования будут отрицательными.
Сколько бы раз они ни выполнялись. Обычно трихомонаде необходимо от 10 до 14 дней для того, чтобы преодолеть порог чувствительности.
При подозрении на заражение этим простейшим сдавать анализы впервые стоит через 2 недели после контакта. Повторять исследование нужно еще через 14 дней.
Если пациент получал лечение, ему также не стоит посещать врача сразу, как курс терапии подойдет к концу.
Если лечение подобрано неверно, велика вероятность того, что микроорганизм лишь опустится в количестве ниже пороговых для исследований значений. В этом случае анализы будут отрицательными до тех пор, пока препараты есть в организме.
Чтобы исключить подобные ошибки, контроль терапии выполняется не раньше, чем через 2 недели после того, как была выпита последняя таблетка.
Когда проводятся контрольные анализы после лечения трихомониаза у женщин?
Терапия заболевания осуществляется препаратами из группы нитроимидазолов.
В случае рецидивирующих форм у женщин некоторые специалисты рекомендуют лечебную вакцину Солкотриховак (эффективность однозначно не доказана).
После завершения антибиотикотерапии контроль излеченности проводят спустя примерно две недели культуральным методом и не ранее чем через месяц при ПЦР-исследовании.
Чтобы сдать анализ на трихомониаз, обращайтесь к автору этой статьи – венерологу в Москве с многолетним опытом работы.
Мазок на трихомониаз: кто может направить на обследование
Нередко больные хотят знать о том, какой врач назначает мазок на трихомониаз.
Ничего удивительного в этом интересе нет, особенно если учесть то, что многие даже частные лаборатории не проводят анализ без направления от лечащего врача. Что уж говорить о государственных учреждениях!
Назначить анализ могут несколько специалистов.
В первую очередь, конечно, стоит обратиться за направлением к венерологу. Поскольку инфекция относится к группе ЗППП, именно венерологи занимаются в основном ее диагностикой и лечением.
В некоторых случаях рекомендовать прохождение обследования и выдать направление на него могут уролог или гинеколог. Это возможно, если доктора при обследовании пациента или пациентки выявили симптомы, характерные для трихомониаза.
Если женщина готовится к ЭКО или пара планирует завести ребенка, обследование может быть рекомендовано врачом-репродуктологом. Доктор назначает его, чтобы избежать проблем в период беременности.
Показания к анализу
Хотя анализ берется и при отсутствии симптомов, особенно он важен при появлении патологических выделений. Это, как правило, белые или желтые жидкие пенистые выделения с тухлым рыбным запахом или без него. Они могут сопровождаться зудом и отеком половых органов, а также болью при половом акте.
Показанием к взятию мазка на трихомониаз также является длительное отсутствие желанной беременности. Сдать мазок на трихомониаз можно в любой частной лаборатории или прямо у лечащего врача.
Условия проведения анализа
Мазок на степень чистоты исследуется не только при трихомониазе, но и при подозрении на гонорею, хламидиоз, кандидоз и др. Взятие анализа проводят при соблюдении определенных условий. Женщина не должна вступать в половые связи и спринцеваться за день до взятия анализа, а также не ходить «по-маленькому» хотя бы 2 часа до исследования.
Мазок на трихомониаз берут и мужчинам из уретры. Однако он малоинформативен из-за небольшого количества бактерий в уретре.